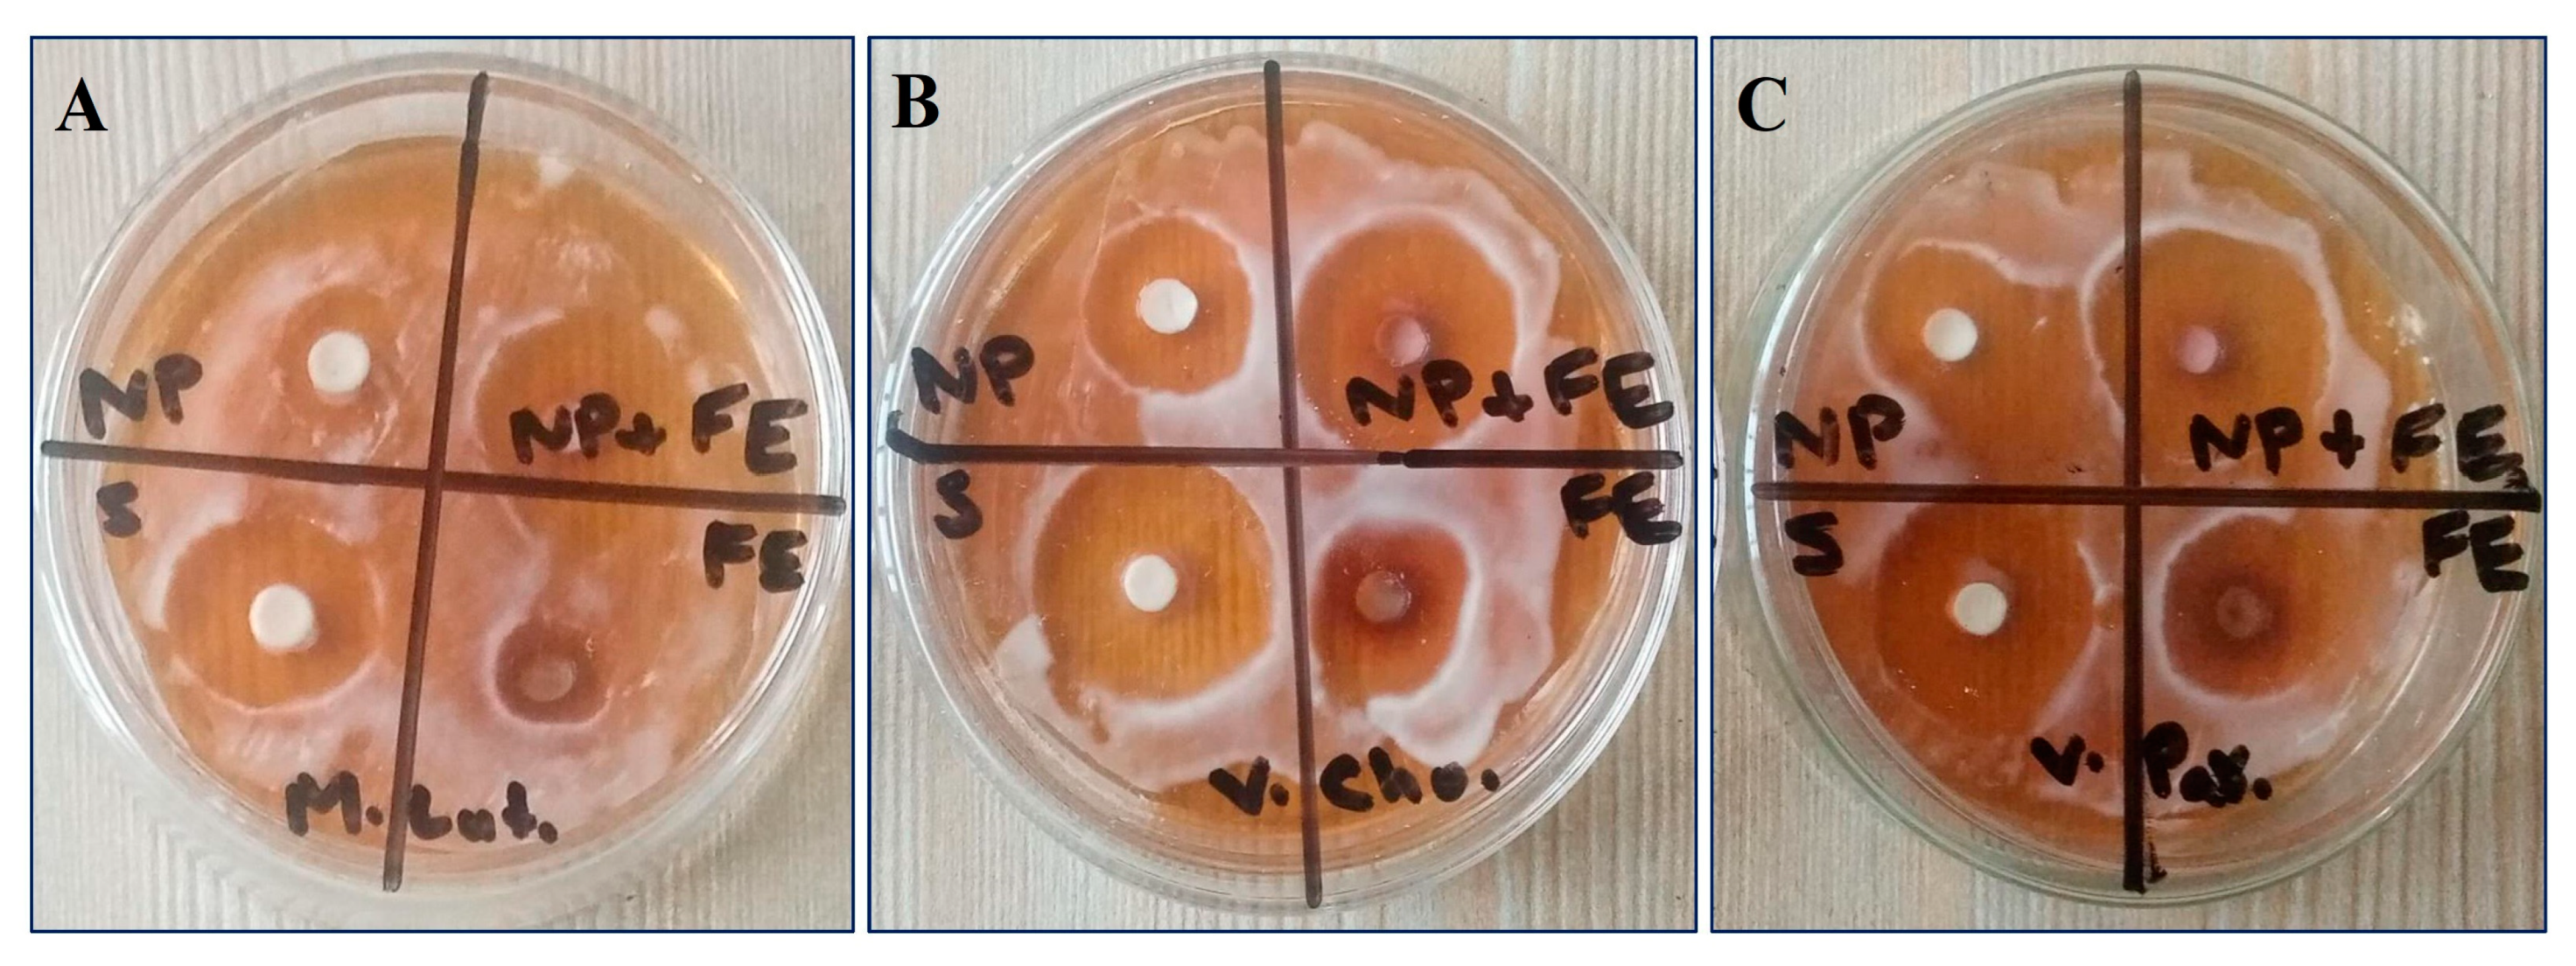
Materials 16 02768 g009

Biosynthesis and Characterization of Calcium Oxide Nanoparticles from Citrullus colocynthis Fruit Extracts; Their Biocompatibility and Bioactivities
Abstract
1. Introduction
2. Materials and Methods
2.1. Ethics Declaration
2.2. Collection of Plants
2.3. Extraction and Phytochemical Analysis
2.4. Green Synthesis and Characterization of Calcium Oxide Nanoparticles
2.5. Stability Analysis of Calcium Oxide Nanoparticles
2.6. In Vitro Release of Calcium Oxide Nanoparticles
2.7. Determination of Cytotoxic Activity
2.7.1. Separation of Peritoneal Macrophages
2.7.2. Maintaining In Vitro Culture of Peritoneal Macrophages
2.7.3. MTT Cytotoxicity Assay
- At = Absorbance by test well;
- Ac = Absorbance by control.
2.7.4. WST-8 Cytotoxicity Assay
- As = Absorbance by sample;
- Ac = Absorbance by control.
2.8. Determination of In Vitro Hemolytic Activity
- At is the absorbance shown by the treatments;
- Ac is the absorbance shown by the control (PBS).
2.9. Determination of Antimicrobial Activity
2.9.1. Microbial Organisms and Culture Medium
2.9.2. Measurement of Inhibition Zones and Activity Index
- ZI (Sample) = Clear zone shown by the sample;
- ZI (Standard) = Clear zone shown by standard drug.
2.10. Determination of Antioxidant Activity
2.10.1. Establishing Test Solutions and Dilutions
2.10.2. DPPH Radical Scavenging Assay (DSRA)
- Ac is absorbance by the control;
- As is absorbance by the sample;
- Ab is absorbance by the blank.
2.11. Statistical Evaluation
3. Results
3.1. Phytochemical Analysis of C. colocynthis Fruit Extract
3.2. Green Synthesis and Characterization of CaONPs
3.2.1. UV-Vis Spectroscopy
3.2.2. Transmission Electron Microscopy (TEM)
3.2.3. X-ray Diffraction (XRD)
3.2.4. Vibrational Properties by FTIR
3.3. Assessment of Stability of CaONPs
3.4. Assessment of In Vitro Release of CaONPs
3.5. Assessment of Cytotoxic Activity
3.6. Assessment of In Vitro Hemolytic Activity
3.7. Assessment of Antimicrobial Activity
3.8. Assessment of Antioxidant Activity
4. Discussion
5. Conclusions
Supplementary Materials
Author Contributions
Funding
Institutional Review Board Statement
Informed Consent Statement
Data Availability Statement
Acknowledgments
Conflicts of Interest
References
- Bayda, S.; Adeel, M.; Tuccinardi, T.; Cordani, M.; Rizzolio, F. The history of nanoscience and nanotechnology: From chemical–physical applications to nanomedicine. Molecules 2019, 25, 112. [Google Scholar] [CrossRef] [PubMed]
- Thangamani, N.; Bhuvaneshwari, N. Green synthesis of gold nanoparticles using Simarouba glauca leaf extract and their biological activity of micro-organism. Chem. Phys. Lett. 2019, 732, 136587. [Google Scholar] [CrossRef]
- Dauthal, P.; Mukhopadhyay, M. Noble metal nanoparticles: Plant-mediated synthesis, mechanistic aspects of synthesis, and applications. Ind. Eng. Chem. Res. 2016, 55, 9557–9577. [Google Scholar] [CrossRef]
- Karlsson, H.L.; Cronholm, P.; Gustafsson, J.; Moller, L. Copper oxide nanoparticles are highly toxic: A comparison between metal oxide nanoparticles and carbon nanotubes. Chem. Res. Toxicol. 2008, 21, 1726–1732. [Google Scholar] [CrossRef]
- Amna, T.; Hassan, M.S.; Gharsan, F.N.; Rehman, S.; Sheikh, F.A. Nanotechnology in drug delivery systems: Ways to boost bioavailability of drugs. In Nanotechnology for Infectious Diseases; Springer: Cham, Switzerland, 2022; pp. 223–236. [Google Scholar] [CrossRef]
- Beigoli, S.; Hekmat, A.; Farzanegan, F.; Darroudi, M. Green synthesis of amorphous calcium phosphate nanopowders using Aloe vera plant extract and assessment of their cytotoxicity and antimicrobial activities. J. Sol-Gel Sci. Technol. 2021, 98, 508–516. [Google Scholar] [CrossRef]
- Yoonus, J.; Resmi, R.; Beena, B. Greener nanoscience: Piper betel leaf extract mediated synthesis of CaO nanoparticles and evaluation of its antibacterial and anticancer activity. Mater. Today Proc. 2021, 41, 535–540. [Google Scholar] [CrossRef]
- Gur, T.; Meydan, I.; Seckin, H.; Bekmezci, M.; Sen, F. Green synthesis, characterization and bioactivity of biogenic zinc oxide nanoparticles. Environ. Res. 2022, 204, 111897. [Google Scholar] [CrossRef]
- Jadhav, V.; Bhagare, A.; Wahab, S.; Lokhande, D.; Vaidya, C.; Dhayagude, A.; Khalid, M.; Aher, J.; Mezni, A.; Dutta, M. Green Synthesized Calcium Oxide Nanoparticles (CaO NPs) Using Leaves Aqueous Extract of Moringa Oleifera and Evaluation of Their Antibacterial Activities. J. Nanomater. 2022, 2022, 9047507. [Google Scholar] [CrossRef]
- Maringgal, B.; Hashim, N.; Tawakkal, I.S.; Hamzah, M.H.; Mohamed, M.T. Biosynthesis of CaO nanoparticles using Trigona sp. Honey: Physicochemical characterization, antifungal activity, and cytotoxicity properties. J. Mater. Res. Technol. 2020, 9, 11756–11768. [Google Scholar] [CrossRef]
- Mohammadi, H.; Nekobahr, E.; Akhtari, J.; Saeedi, M.; Akbari, J.; Fathi, F. Synthesis and characterization of magnetite nanoparticles by co-precipitation method coated with biocompatible compounds and evaluation of in-vitro cytotoxicity. Toxicol. Rep. 2021, 8, 331–336. [Google Scholar] [CrossRef]
- Sobierajska, P.; Pozniak, B.; Tikhomirov, M.; Miller, J.; Mrowczynska, L.; Piecuch, A.; Rewak-Soroczynska, J.; Dorotkiewicz-Jach, A.; Drulis-Kawa, Z.; Wiglusz, R.J. Multifunctionality of nanosized calcium apatite dual-doped with Li+/Eu3+ ions related to cell culture studies and cytotoxicity evaluation in vitro. Biomolecules 2021, 11, 1388. [Google Scholar] [CrossRef]
- Tabrizi, H.M.S.S.; Samareh, M.S.; Kazemi, R. Green synthesis of calcium oxide nanoparticles in Linum usitatissimum extract and investigation of their photocatalytic and cytotoxicity effects. Biomass Convers. Biorefinery 2022, 1–10. [Google Scholar] [CrossRef]
- Al-Maula, B.H.; Wally, Z.J.; Al-Magsoosi, M.J.; Dosh, R.H.; Mustafa, R.M.; Al-Nasrawi, S.J.; Alfutimie, A.; Haider, J. Studying Effects of Calcium Oxide Nanoparticles on Dentinogenesis in Male Wistar Rats. Int. J. Dent. 2021, 2021, 9983538. [Google Scholar] [CrossRef] [PubMed]
- Pathania, D.; Kumar, S.; Thakur, P.; Chaudhary, V.; Kaushik, A.; Varma, R.S.; Furukawa, H.; Sharma, M.; Khosla, A. Essential oil-mediated biocompatible magnesium nanoparticles with enhanced antibacterial, antifungal, and photocatalytic efficacies. Sci. Rep. 2022, 12, 11431. [Google Scholar] [CrossRef] [PubMed]
- Li, Q.Y.; Munawar, M.; Saeed, M.; Shen, J.Q.; Khan, M.S.; Noreen, S.; Alagawany, M.; Naveed, M.; Madni, A.; Li, C.X. Citrullus colocynthis (L.) Schrad (Bitter Apple Fruit): Promising traditional uses, pharmacological effects, aspects, and potential applications. Front. Pharmacol. 2022, 12, 3848. [Google Scholar] [CrossRef]
- Kim, Y.C.; Choi, D.; Zhang, C.; Liu, H.F.; Lee, S. Profiling cucurbitacins from diverse watermelons (Citrullus spp.). Hortic. Environ. Biotechnol. 2018, 59, 557–566. [Google Scholar] [CrossRef]
- Al-Nablsi, S.; El-Keblawy, A.; Ali, M.A.; Mosa, K.A.; Hamoda, A.M.; Shanableh, A.; Soliman, S.S. Phenolic contents and antioxidant activity of Citrullus colocynthis fruits, growing in the hot arid desert of the UAE, influenced by the fruit parts, accessions, and seasons of fruit collection. Antioxidants 2022, 11, 656. [Google Scholar] [CrossRef]
- Marzouk, B.; Refifà, M.; Montalbano, S.; Buschini, A.; Negri, S.; Commisso, M.; Degola, F. In Vitro Sprouted Plantlets of Citrullus colocynthis (L.) Schrad Shown to Possess Interesting Levels of Cucurbitacins and Other Bioactivities against Pathogenic Fungi. Plants 2022, 11, 2711. [Google Scholar] [CrossRef]
- Nagore, P.; Ghotekar, S.; Mane, K.; Ghoti, A.; Bilal, M.; Roy, A. Structural properties and antimicrobial activities of Polyalthia longifolia leaf extract-mediated CuO nanoparticles. BioNanoScience 2021, 11, 579–589. [Google Scholar] [CrossRef]
- Roy, A.; Khan, A.; Ahmad, I.; Alghamdi, S.; Rajab, B.S.; Babalghith, A.O.; Islam, M. Flavonoids a bioactive compound from medicinal plants and its therapeutic applications. BioMed Res. Int. 2022, 2022, 5445291. [Google Scholar] [CrossRef]
- Nipunika, U.; Jayaneththi, Y.; Sewwandi, G.A. Synthesis of Calcium Oxide Nanoparticles from Waste Eggshells. In Proceedings of the 2022 Moratuwa Engineering Research Conference (MERCon), Moratuwa, Sri Lanka, 27—29 July 2022; pp. 1–15. [Google Scholar] [CrossRef]
- Hu, K.; Wang, H.; Liu, Y.; Yang, C. KNO3/CaO as cost-effective heterogeneous catalyst for the synthesis of glycerol carbonate from glycerol and dimethyl carbonate. J. Ind. Eng. Chem. 2015, 28, 334–343. [Google Scholar] [CrossRef]
- Mazher, M.; Anjum, M.; Mushtaq, W.; Noshad, Q.; Malik, N.Z. Antifungal assay of Solanum nigrum Linn. fruit, leaves and stems extracts in different solvents. Int. J. Biosci. 2017, 10, 380–385. [Google Scholar] [CrossRef]
- Harborne, J.B. Methods of plant analysis. In Phytochemical Methods: A Guide to Modern Techniques of Plant Analysis; Springer: Cham, Switzerland, 1973; pp. 1–32. [Google Scholar]
- Harith, S.S.; Mazlun, M.H.; Mydin, M.M.; Nawi, L.; Saat, R. Studies on phytochemical constituents and antimicrobial properties of Citrullus lanatus peels. Malays. J. Anal. Sci. 2018, 22, 151–156. [Google Scholar] [CrossRef]
- Ramli, M.; Rossani, R.B.; Nadia, Y.; Darmawan, T.B.; Ismail, Y.S. Nanoparticle fabrication of calcium oxide (CaO) mediated by the extract of red dragon fruit peels (Hylocereus polyrhizus) and its application as inorganic–anti-microorganism materials. Mater. Sci. Eng. 2019, 509, 012090. [Google Scholar] [CrossRef]
- Ahmad, J.H.; Šurina, I.; Zaman, A.; Al-Fatesh, A.S.; Rahim, F.; Al-Otaibi, R.L. Synthesis of Biodiesel from Ricinus communis L. Seed Oil, a Promising Non-Edible Feedstock Using Calcium Oxide Nanoparticles as a Catalyst. Energies 2022, 15, 6425. [Google Scholar] [CrossRef]
- Khine, E.E.; Koncz-Horvath, D.; Kristaly, F.; Ferenczi, T.; Karacs, G.; Baumli, P.; Kaptay, G. Synthesis and characterization of calcium oxide nanoparticles for CO2 capture. J. Nanoparticle Res. 2022, 24, 139. [Google Scholar] [CrossRef]
- Marquis, G.; Ramasamy, B.; Banwarilal, S.; Munusamy, A.P. Evaluation of antibacterial activity of plant mediated CaO nanoparticles using Cissus quadrangularis extract. J. Photochem. Photobiol. B Biol. 2016, 155, 28–33. [Google Scholar] [CrossRef]
- Leonard, K.; Ahmmad, B.; Okamura, H.; Kurawaki, J. In situ green synthesis of biocompatible ginseng capped gold nanoparticles with remarkable stability. Colloids Surf. B Biointerfaces 2011, 82, 391–396. [Google Scholar] [CrossRef]
- Peng, Q.; Sun, X.; Gong, T.; Wu, C.Y.; Zhang, T.; Tan, J.; Zhang, Z.R. Injectable and biodegradable thermosensitive hydrogels loaded with PHBHHx nanoparticles for the sustained and controlled release of insulin. Acta Biomater. 2013, 9, 5063–5069. [Google Scholar] [CrossRef]
- Mosmann, T. Rapid colorimetric assay for cellular growth and survival: Application to proliferation and cytotoxicity assays. J. Immunol. Methods 1983, 65, 55–63. [Google Scholar] [CrossRef]
- Ray, A.; Dittel, B.N. Isolation of mouse peritoneal cavity cells. J. Vis. Exp. 2010, 35, 1488. [Google Scholar]
- Kumar, J.; Mitra, M.D.; Hussain, A.; Kaul, G. Exploration of immunomodulatory and protective effect of Withania somnifera on trace metal oxide (zinc oxide nanoparticles) induced toxicity in Balb/c mice. Mol. Biol. Rep. 2019, 46, 2447–2459. [Google Scholar] [CrossRef]
- Oves, M.; Khan, M.S.; Zaidi, A.; Ahmed, A.S.; Ahmed, F.; Ahmad, E.; Sherwani, A.; Owais, M.; Azam, A. Antibacterial and cytotoxic efficacy of extracellular silver nanoparticles biofabricated from chromium reducing novel OS4 strain of Stenotrophomonas maltophilia. PLoS ONE 2013, 8, e59140. [Google Scholar] [CrossRef] [PubMed]
- Perez, C. Antibiotic assay by agar-well diffusion method. Acta Biol. Med. Exp. 1990, 15, 113–115. [Google Scholar]
- Mazher, M.; Malik, N.Z.; Riaz, M.; Hussain, A.; Ali, Y.; Noshad, Q. Phytochemistry and antibacterial assay of fruit leaf and stem extracts of Solanum nigrum L. in different solvent. Int. J. Biosci. 2016, 9, 129–136. [Google Scholar] [CrossRef]
- Maqbool, M.; Ajaib, M.; Ishtiaq, M.; Mushtaq, W.; Azam, S.; Haroon, M.; Azam, A.; Shahzaman, M. Investigation of Antimicrobial and Antioxidant Activities of Cirsium arvensis (L.) Scop from District Bhimber of Azad Jammu and Kashmir. J. Chem. Soc. Pakistan 2017, 39, 1. [Google Scholar]
- Brand-Williams, W.; Cuvelier, M.E.; Berset, C.L. Use of a free radical method to evaluate antioxidant activity. LWT Food Sci. Technol. 1995, 28, 25–30. [Google Scholar] [CrossRef]
- Aleixandre-Tudo, J.L.; Du Toit, W. The role of UV-visible spectroscopy for phenolic compounds quantification in winemaking. In Frontiers and New Trends in the Science of Fermented Food and Beverages; InTech Open: London, UK, 2018; pp. 200–204. [Google Scholar]
- Gierschner, J.; Duroux, J.L.; Trouillas, P. UV/Visible spectra of natural polyphenols: A time-dependent density functional theory study. Food Chem. 2012, 131, 79–89. [Google Scholar] [CrossRef]
- Gandhi, N.; Shruthi, Y.; Sirisha, G.; Anusha, C.R. Facile and eco-friendly method for synthesis of calcium oxide (CaO) nanoparticles and its potential application in agriculture. Haya Saudi J. Life Sci. 2021, 6, 89–103. [Google Scholar] [CrossRef]
- Ramola, B.; Joshi, N.C.; Ramola, M.; Chhabra, J.; Singh, A. Green synthesis, characterizations and antimicrobial activities of CaO nanoparticles. Orient. J. Chem. 2019, 35, 1154. [Google Scholar] [CrossRef]
- Hussein, M.; Zaki, A.; Abdel-Raouf, N.; Alsamhary, K.; Fathy, W.; Abdelhameed, M.; Elsayed, K. Flocculation of microalgae using calcium oxide nanoparticles; process optimization and characterization. Int. Aquat. Res. 2022, 14, 63. [Google Scholar] [CrossRef]
- Mostafa, F.A.; Gad, A.N.; Gaber, A.A.; Abdel-Wahab, A.M. Preparation, Characterization and Application of Calcium Oxide Nanoparticles from Waste Carbonation Mud in Clarification of Raw Sugar Melt. Sugar Tech. 2022, 25, 331–338. [Google Scholar] [CrossRef]
- Drissi, F.; Lahfa, F.; Gonzalez, T.; Peiretti, F.; Tanti, J.F.; Haddad, M.; Govers, R. A Citrullus colocynthis fruit extract acutely enhances insulin-induced GLUT4 translocation and glucose uptake in adipocytes by increasing PKB phosphorylation. J. Ethnopharmacol. 2021, 270, 113772. [Google Scholar] [CrossRef]
- Afzal, M.; Khan, A.S.; Zeshan, B.; Riaz, M.; Ejaz, U.; Saleem, A.; Ahmed, N. Characterization of Bioactive Compounds and Novel Proteins Derived from Promising Source Citrullus colocynthis along with In-Vitro and In-Vivo Activities. Molecules 2023, 28, 1743. [Google Scholar] [CrossRef]
- Kouzu, M.; Kasuno, T.; Tajika, M.; Sugimoto, Y.; Yamanaka, S.; Hidaka, J. Calcium oxide as a solid base catalyst for transesterification of soybean oil and its application to biodiesel production. Fuel 2008, 87, 2798–2806. [Google Scholar] [CrossRef]
- Sadeghi, M.; Husseini, M.H. A novel method for the synthesis of CaO nanoparticle for the decomposition of sulfurous pollutant. J. Appl. Chem. Res. 2013, 7, 39–49. [Google Scholar]
- D’Souza, S. A Review of In Vitro Drug Release Test Methods for Nano-Sized Dosage Forms. Adv. Pharm. 2014, 2014, 304757. [Google Scholar] [CrossRef]
- Abu-Huwaij, R.; Abbas, M.M.; Al-Shalabi, R.; Almasri, F.N. Synthesis of transdermal patches loaded with greenly synthesized zinc oxide nanoparticles and their cytotoxic activity against triple negative breast cancer. Appl. Nanosci. 2022, 12, 69–78. [Google Scholar] [CrossRef]
- Yesil-Celiktas, O.; Cetin-Uyanikgil, E.O. In vitro release kinetics of polycaprolactone encapsulated plant extract fabricated by supercritical antisolvent process and solvent evaporation method. J. Supercrit. Fluids 2012, 62, 219–225. [Google Scholar] [CrossRef]
- de Oliveira, J.R.; de Castro, V.C.; Vilela, P.D.G.F.; Camargo, S.E.A.; Carvalho, C.A.T.; Jorge, A.O.C.; de Oliveira, L.D. Cytotoxicity of Brazilian plant extracts against oral microorganisms of interest to dentistry. BMC Complement. Altern. Med. 2013, 13, 208. [Google Scholar] [CrossRef]
- Naik, S.K.; Mohanty, S.; Padhi, A.; Pati, R.; Sonawane, A. Evaluation of antibacterial and cytotoxic activity of Artemisia nilagirica and Murraya koenigii leaf extracts against mycobacteria and macrophages. BMC Complement. Altern. Med. 2014, 14, 87. [Google Scholar] [CrossRef] [PubMed]
- Alayed, H.S.; Devanesan, S.; AlSalhi, M.S.; Alkindi, M.G.; Alghamdi, O.G.; Alkhalaf, R.I. Green synthesis of calcium hydroxide nanoparticles using carob fruit extract and evaluation of their cytotoxic activity. Appl. Nanosci. 2022, 12, 2511–2521. [Google Scholar] [CrossRef]
- de Souza, G.L.; Silva, A.C.; Dantas, N.O.; Turrioni, A.P.; Moura, C.C. Cytotoxicity and effects of a new calcium hydroxide nanoparticle material on production of reactive oxygen species by LPS-stimulated dental pulp cells. Iran. Endod. J. 2020, 15, 227–235. [Google Scholar] [CrossRef] [PubMed]
- Eram, R.; Kumari, P.; Panda, P.K.; Singh, S.; Sarkar, B.; Mallick, M.A.; Verma, S.K. Cellular investigations on mechanistic biocompatibility of green synthesized calcium oxide nanoparticles with Danio rerio. J. Nanotheranostics 2021, 2, 51–62. [Google Scholar] [CrossRef]
- Barbinta-Patrascu, M.E.; Badea, N.; Pirvu, C.; Bacalum, M.; Ungureanu, C.; Nadejde, P.L.; Rau, I. Multifunctional soft hybrid bio-platforms based on nano-silver and natural compounds. Mater. Sci. Eng. C 2016, 69, 922–932. [Google Scholar] [CrossRef]
- Essawy, E.; Abdelfattah, M.S.; El-Matbouli, M.; Saleh, M. Synergistic effect of biosynthesized silver nanoparticles and natural phenolic compounds against drug-resistant fish pathogens and their cytotoxicity: An in vitro study. Mar. Drugs 2021, 19, 22. [Google Scholar] [CrossRef] [PubMed]
- Majeed, M.; Hakeem, K.R.; Rehman, R.U. Synergistic effect of plant extract coupled silver nanoparticles in various therapeutic applications-present insights and bottlenecks. Chemosphere 2022, 288, 132527. [Google Scholar] [CrossRef]
- Liu, Y.S.; Chang, Y.C.; Chen, H.H. Silver nanoparticle biosynthesis by using phenolic acids in rice husk extract as reducing agents and dispersants. J. Food Drug Anal. 2018, 26, 649–656. [Google Scholar] [CrossRef]
- Rao, V.; Poonia, A. Citrullus colocynthis (bitter apple): Bioactive compounds, nutritional profile, nutraceutical properties and potential food applications: A review. Food Prod. Process. Nutr. 2023, 5, 4. [Google Scholar] [CrossRef]
- Ahmad, W.; Kamboj, A.; Banerjee, I.; Jaiswal, K.K. Pomegranate peels mediated synthesis of calcium oxide (CaO) nanoparticles, characterization, and antimicrobial applications. Inorg. Nano-Met. Chem. 2022, 2, 1–8. [Google Scholar] [CrossRef]
- Ikram, M.; Saeed, M.; Haider, J.; Haider, A.; Ul-Hamid, A.; Shahzadi, A.; Nabgan, W.; Rafique, A.; Dilpazir, S.; Ali, S. Facile synthesis of chitosan-grafted polyacrylic acid-doped CaO nanoparticle for catalytic and antimicrobial potential. Appl. Nanosci. 2022, 12, 2657–2670. [Google Scholar] [CrossRef]
- Khatri, S.; Faizi, S.; Fayyaz, S.; Iqbal, E. Citrullus colocynthis: A Treasure of Phytochemical, Pharmacological, Pesticidal and Nematicidal Compounds. Pak. J. Nematol. 2021, 39, 122–150. [Google Scholar] [CrossRef]
- Kandiah, K.; Jeevanantham, T.; Ramasamy, B. Reliability of antioxidant potential and in vivo compatibility with extremophilic actinobacterial-mediated magnesium oxide nanoparticle synthesis. Artif. Cells Nanomed. Biotechnol. 2019, 47, 862–872. [Google Scholar] [CrossRef] [PubMed]

| Sr. | Phytochemical | Method | Point of Confirmation | Affirmation |
|---|---|---|---|---|
| 01 | Alkaloid | Dragendorff test | Formation of Red precipitates | +++ |
| Hager tests | Appearance of yellow color | +++ | ||
| Mayer test | Formation of yellow precipitates | +++ | ||
| Wagner test | Formation of reddish-brown precipitates | +++ | ||
| 02 | Flavonoid | Alkaline reagent test | Disappearance of color | + |
| Lead acetate test | Formation of yellow precipitates | + | ||
| Magnesium ribbon test | Change in color from orange to red | ++ | ||
| 03 | Glycosides | Bromine water test | Appearance of brownish color | ++ |
| Keller test | Formation of dark brown ring at surface | ++ | ||
| 04 | Phenols | Ferric chloride test | Appearance of bluish green color | +++ |
| 05 | Saponins | Froth test | Formation of persistent froth | ++ |
| 06 | Tannins | Ferric chloride test | Appearance of blackish color | + |
| 07 | Terpenoids | Liebermann Burchard’s test | Formation of brown ring at surface | +++ |
| Salkowski’s test | Appearance of reddish color | +++ |
| Treatments | Microccus luteus | Vibrio cholerae | Vibrio parahaemolyticus | |||
|---|---|---|---|---|---|---|
| ZI | AI | ZI | AI | ZI | AI | |
| CaONPs | 7.3 ± 0.3 a | 0.29 | 11.8 ± 0.2 a | 0.39 | 10.4 ± 1.2 a | 0.4 |
| CCFE | 8.1 ± 0.5 b | 0.33 | 12.2 ± 0.6 a | 0.4 | 12.1 ± 0.4 b | 0.44 |
| SynS | 25.6 ± 1.1 d | 1.03 | 28.5 ± 0.3 b | 0.94 | 27.2 ± 1.3 c | 0.99 |
| Streptomycin | 24.8 ± 1.6 c | 30.2 ± 0.7 c | 27.4 ± 0.8 c | |||
| Treatments | Concentration | |||
|---|---|---|---|---|
| 250 µL/mL | 500 µL/mL | 1000 µL/mL | 2000 µL/mL | |
| CaONPs | 31.97 ± 0.91 a | 35.55 ± 0.92 a | 41.19 ± 0.38 a | 49.88 ± 0.16 a |
| CCFE | 49.97 ± 1.09 b | 57.60 ± 0.59 b | 61.37 ± 1.19 b | 68.25 ± 0.37 b |
| SynS | 65.90 ± 0.97 c | 73.54 ± 0.69 c | 81.84 ± 3.14 c | 83.87 ± 1.68 c |
| Control (BHT) | 71.48 ± 0.09 d | 76.80 ± 2.72 d | 84.74 ± 4.09 d | 89.42 ± 4.19 d |
Disclaimer/Publisher’s Note: The statements, opinions and data contained in all publications are solely those of the individual author(s) and contributor(s) and not of MDPI and/or the editor(s). MDPI and/or the editor(s) disclaim responsibility for any injury to people or property resulting from any ideas, methods, instructions or products referred to in the content. |
© 2023 by the authors. Licensee MDPI, Basel, Switzerland. This article is an open access article distributed under the terms and conditions of the Creative Commons Attribution (CC BY) license (https://creativecommons.org/licenses/by/4.0/).
Share and Cite
Mazher, M.; Ishtiaq, M.; Hamid, B.; Haq, S.M.; Mazhar, A.; Bashir, F.; Mazhar, M.; Mahmoud, E.A.; Casini, R.; Alataway, A.; et al. Biosynthesis and Characterization of Calcium Oxide Nanoparticles from Citrullus colocynthis Fruit Extracts; Their Biocompatibility and Bioactivities. Materials 2023, 16, 2768. https://doi.org/10.3390/ma16072768
Mazher M, Ishtiaq M, Hamid B, Haq SM, Mazhar A, Bashir F, Mazhar M, Mahmoud EA, Casini R, Alataway A, et al. Biosynthesis and Characterization of Calcium Oxide Nanoparticles from Citrullus colocynthis Fruit Extracts; Their Biocompatibility and Bioactivities. Materials. 2023; 16(7):2768. https://doi.org/10.3390/ma16072768
Chicago/Turabian StyleMazher, Mubsher, Muhammad Ishtiaq, Bilqeesa Hamid, Shiekh Marifatul Haq, Atiya Mazhar, Faiza Bashir, Mussaddaq Mazhar, Eman A. Mahmoud, Ryan Casini, Abed Alataway, and et al. 2023. "Biosynthesis and Characterization of Calcium Oxide Nanoparticles from Citrullus colocynthis Fruit Extracts; Their Biocompatibility and Bioactivities" Materials 16, no. 7: 2768. https://doi.org/10.3390/ma16072768
APA StyleMazher, M., Ishtiaq, M., Hamid, B., Haq, S. M., Mazhar, A., Bashir, F., Mazhar, M., Mahmoud, E. A., Casini, R., Alataway, A., Dewidar, A. Z., & Elansary, H. O. (2023). Biosynthesis and Characterization of Calcium Oxide Nanoparticles from Citrullus colocynthis Fruit Extracts; Their Biocompatibility and Bioactivities. Materials, 16(7), 2768. https://doi.org/10.3390/ma16072768







